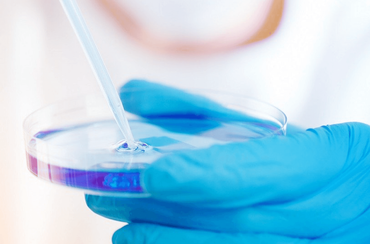
Mikrobiologische Untersuchung auf Schadstoffe und krankmachende Keime Mikrobiologische Untersuchung auf Schadstoffe und krankmachende Keime

sauber und sicher
Wir warten und reinigen Lüftungsanlagen
Damit Ihnen nicht die Luft wegbleibt:
Den Wert Ihres Eigenheimes sichern und erhalten
Damit Ihnen nicht die Luft wegbleibt:
Den Wert Ihres Eigenheimes sichern und erhalten
Komplexe Lüftungsanlagen haben längst auch in private Wohngebäude Einzug gehalten. Wie andere Systeme auch, müssen sie regelmäßig gewartet, gereinigt und instandgesetzt
werden, um eine perfekte Be- und Entlüftung sicherzustellen.
Kontrollierte Wohnraumlüftung (KWL) sorgt für ein optimales Haus- und Wohnklima, das Schimmelbildung verhindert, Allergien reduziert und die Gesundheit der Bewohner erhält.
Selbstverständlich bieten wir auch privaten Hausbesitzern eine umfassende Dokumentation unserer Maßnahmen, damit sie den Werterhalt ihrer Immobilie dokumentieren können.
Vorher - Nachher
Was können wir für Sie tun?
Öffnungszeiten
Mo – Fr 9.00 bis 17.00 Uhr